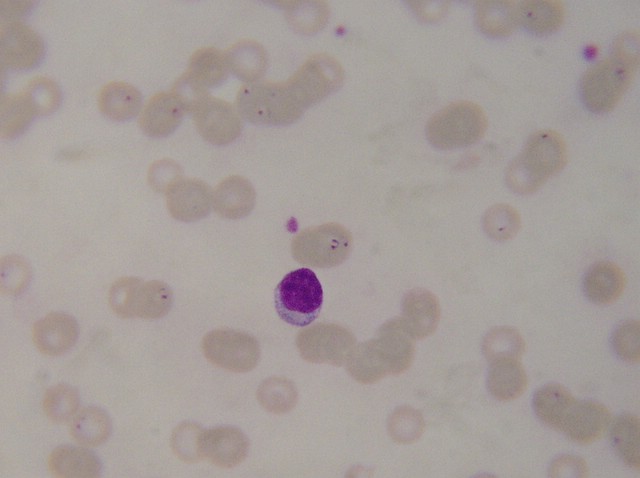
�@΢�R���Ĕz��Ȯ���x(ch��ng)

信息分類:站內(nèi)新聞
作者:yiyi發(fā)布
時(shí)間:2012-2-10 0:25:35
將本頁(yè)加入收藏
下一篇:偽步行蟲(chóng)簡(jiǎn)介,危害植物?成長(zhǎng)情況?顯微鏡百科
上一篇:家里有臺(tái)顯微鏡這是我給狗狗顯微鏡下拍攝的細(xì)菌照片!
點(diǎn)擊查看產(chǎn)品參數(shù)和報(bào)價(jià)--丨--
---
---
---
正文:
狗狗的得了犬焦蟲(chóng),家里有一臺(tái)顯微鏡,正好就用來(lái)確診,檢查了下 這是拍攝的照片
合作伙伴: